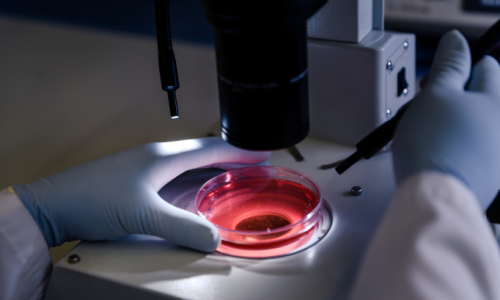
Rectangle 16

The Egyptian Society for Haematology (ESH) has been bringing haematology professionals together since 1977 to transform the care our members provide to patients. With over 800 members. We are the largest Egypt haematology organisation and the only society

It is my great pleasure to welcome you to the 40th Annual International Conference of the Egyptian Society of haematology at Triumph Luxury Hotel, New Cairo, Egypt. ESH is truly unique as it is the only meeting that gathers friends and colleagues from different haematology disciplines from all over the world focusing exclusively on haematologic diseases and the ways we can improve the quality of services offered to our patients.
For more than four decades, ESH has acquired an excellent reputation among practicing haematologists and allied health professionals as the optimal forum for sharing advances, updates and new information in all areas of haematology.
It is undoubtedly an excellent opportunity for interactions between clinical haematology, paediatric haematology and laboratory haematology communities. Once again this year, it’s fantastic to be meeting to discuss and debate the challenges we all face in the field of haematology and to map out strategies and propose solutions to address those challenges.
The scientific program will bring together a range of excellent Egyptian and foreign guest speakers, which is already a tradition in ESH conferences, valuing expertise as well as offering opportunities to young scientists. This year the Scientific Program will encompass different aspects in haematology including flow cytometry, cytogenetics, next-generation sequencing, transfusion medicine, quality, stem cell transplantation, and new targeted therapies.
Please make sure that you take the opportunity to discuss, debate, collaborate, make new connections and renew existing ones to make the most of your time in the conference and please ensure that you also enjoy the social events we have organised as part of the conference program…Keep Connected.

Medical Sponsor Companies
















Join Us – become one of the Egyptian
Society of haematology
fermentum. Sed arcu nulla vitae vulputate vestibulum quis venenatis. Purus ut cursus ultrices velit
dui arcu. Nam consectetur integer a sit praesent enim
The Egyptian Society for Haematology (ESH) has been bringing haematology
professionals together since 1977 to transform the care our members provide
to patients. With over 800 members. We are the largest Egypt
haematology organisation and the only society